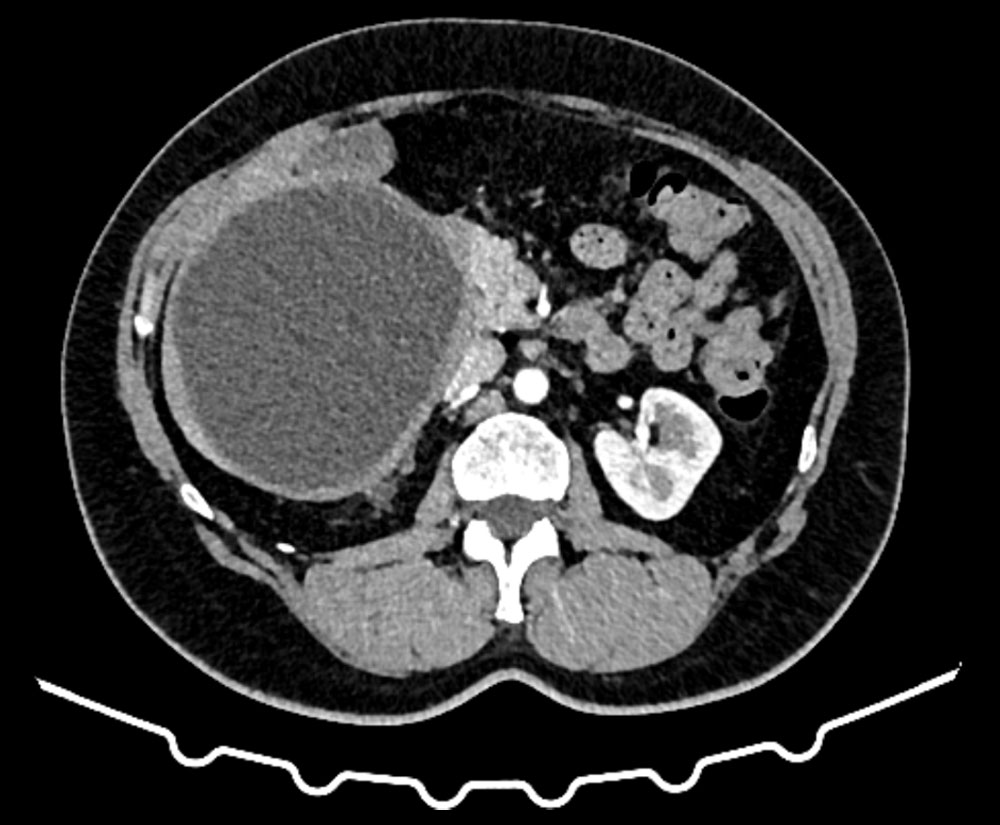

Кисты органов брюшной полости могут быть случайной находкой во время диспансерного обследования пациентов или же быть причиной различных недомоганий (таких как тяжесть в верхних отделах живота, слабость, тошнота, увеличение живота в размерах и др.).
Причину возникновения кист достоверно установить получается не всегда. По происхождению кисты бывают паразитарные и непаразитарные. Паразитарные кисты являются следствием заражения организма паразитом, которым чаще всего является Эхиноккок (рис. 1).
Непаразитарные кисты могут быть врождённой особенностью (истинная киста) или являться последствием перенесенной ранее травмы (псевдокиста) (рис. 2). Кисты печени могут быть следствием перенесённых ранее операций, содержимым таких кист может быть желчь.

Рис. 2. КТ псевдокисты селезёнки
С целью диагностики и определения тактики лечения используются лабораторные и инструментальные методы: стандартные анализы дополняются серологическими тестами на выявление паразитарной активности и опухолевыми маркёрами (СА19,9; РЭА); ультразвуковая диагностика, компьютерная томография с внутривенным контрастированием, магнитно-резонансная томография. В Пироговском Центре возможно прохождение всех этапов диагностики на самом современном оборудовании (рис. 3, рис. 4).
Лечение кист паразитарной природы проводится совместно с врачами-инфекционистами-паразитологами. В зависимости от состояния кисты, сроков давности её образования, активности паразита лечебная тактика может включать и лекарственную терапию, и выполнение малоинвазивного оперативного лечения и/или применение лапароскопического/открытого оперативного вмешательства.
Непаразитарные кисты органов брюшной полости в ряде случаев требуют наблюдения, лечебная тактика определяется в индивидуальном порядке в зависимости от размеров этих новообразований, наличия или отсутствия симптомов, динамики увеличения размеров кисты. Маленькие кисты могут длительно наблюдаться в амбулаторном порядке и не требовать оперативного лечения.
Крупные (от 5 см и более) или быстро растущие кисты необходимо удалять в связи с увеличением риска возникновения осложнений: перфорации с излитием содержимого в брюшную полость, кровотечения, инфицирования, возникновения нарушений в работе органов вовлечённых в образование кист или сдавления рядом лежащих структур, а также вероятностью прогрессирования разрушения паренхимы печени.
Выбор метода оперативного лечения определяется в зависимости от объёма и локализации кисты. В Пироговском Центре первым этапом всегда рассматривается вопрос использования малоинвазивных методик: пункция и дренирование (эвакуация жидкостного содержимого) под сочетанным контролем ультразвукового и рентгеновского аппаратов, этаноловая деструкция (воздействие на внутренний оболочки кисты, так называемая деэпителизация) или эндоваскулярная эмболизация (прекращение кровоснабжение кисты).
Пункция и дренирование проводится маленьким (несколько мм) разрезом на передней брюшной стенке, через который в полость кисты вводится специальный проводник (дренаж) и эвакуируется её содержимое. Далее в оставшуюся полость вводятся специальные склерозирующие (склеивающие) вещества. После операции через этот же прокол на передней брюшной стенке остаётся специальная дренажная трубка, через которую врач контролирует наличие отделяемого из полости или последующее введение склерозирующего препарата. Может потребоваться от

Рис. 5. Пункция, дренирование кист брюшной полости под УЗИ- и РТВ-наведением
Суть эндоваскулярной эмболизации заключается в прекращении кровоснабжении образования. Через периферический сосуд специальным проводником в питающую артерию вводится эмболизирующее вещество, которое препятствует дальнейшему полноценному «питанию» образования. Пациенты хорошо переносят данную манипуляцию и в короткие сроки активизируются. До полного прекращения кровоснабжения может потребоваться от
Такие вмешательства проходят на фоне комбинированного наркоза: седации и местной анестезии. Пациент засыпает, не чувствует боли, но продолжает самостоятельно дышать.
При невозможности выполнения или неэффективности малоинвазивных методик рассматривается вариант лапароскопического оперативного лечения, при невозможности выполнения лапароскопической операции проводится открытая операция. Окончательный объём оперативного лечения определяется хирургом интраоперационно, но преимущество всегда отдаётся меньшему объёму операции (резекция кисты с максимально возможным сохранением органа). При вовлечении желчного пузыря, рассматривается вопрос о выполнении холецистэктомии. При оперативном лечении кист селезёнки также возможно использование малоинвазивных методик, однако в связи с особенностями строения органа нередко показано выполнение спленэктомии.
Гемангиомы печени и селезёнки являются доброкачественными новообразованиями органов брюшной полости. Чаще всего оказываются случайной находкой во время проведения ультразвукового исследования органов брюшной полости, однако могут проявляться симптомами (рис.6).
Оперативное лечение гемангиом органов брюшной полости показано при их большом размере или быстром темпе роста в связи с риском возникновения внутрибрюшного кровотечения. В Хирургическом отделении Пироговского Центра преимущество отдаётся мини-инвазивному методу контроля роста гемангиом-эндоваскулярной эмболизации новообразований, при котором само новообразование не удаляется, однако блокируется питающий сосуд, что позволяет уменьшить или полностью остановить рост гемангиомы. При неэффективности или невозможности выполнения мини-инвазивного вмешательства рассматривается вопрос о лапароскопической или открытой операции.